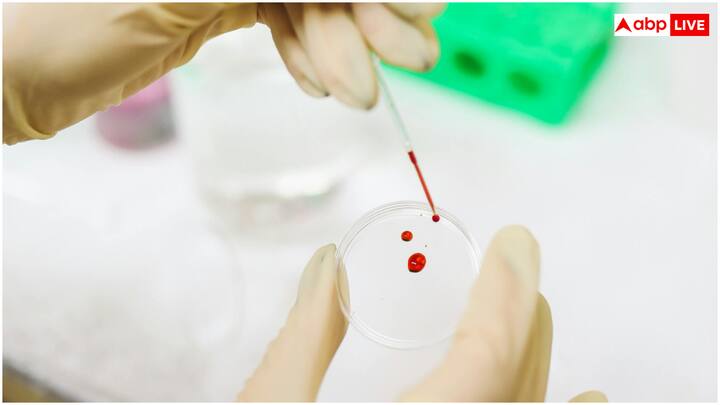
अस्पताल के सीएमओ डॉ. प्रभाकर रेड्डी ने बताया कि इस तकनीक ने 95% से अधिक सटीक नतीजे दिए हैं, जो पारंपरिक ब्लड टेस्ट के बराबर हैं. उन्होंने कहा, 'यह तकनीक उन मरीजों के लिए वरदान साबित होगी, जो सुई से डरते हैं या जिन्हें बार-बार ब्लड टेस्ट करवाने पड़ते हैं.'

एक्सप्लोरर
ब्लड टेस्ट करने की आई नई तकनीक! न लगेगी सुई और नहीं होगा दर्द, बस चेहरे होगा स्कैन और...
किसी भी बीमारी की जांच के लिए ब्लड टेस्ट कराना जरूरी होता है और उसके लिए लगने वाली सुई और दर्द का खौफ लगभग हर इंसान के मन में होता है.
अब ब्लड टेस्ट करने की नई तकनीक आ गई है, जिसमें न सुई लगेगी और न ही दर्द होगा. बस चेहरा स्कैन होगा और ब्लड रिपोर्ट मिल जाएगी. आइए इस तकनीक के बारे में विस्तार से जानते हैं.
1/7

गौरतलब है कि हैदराबाद के नीलोफर अस्पताल में हाल ही में एक नई तकनीक 'अमृत स्वस्थ भारत' लॉन्च की गई. यह एआई आधारित एक डायग्नोस्टिक टूल है.
2/7

यह टूल महज 20 से 60 सेकंड में चेहरे को स्कैन करके ब्लड टेस्ट की पूरी रिपोर्ट दे देता है. इस तकनीक से सिर्फ चेहरे को स्कैन करके 10 से ज्यादा जांच हो जाती हैं.
3/7

'अमृत स्वस्थ भारत' एआई-आधारित डायग्नोस्टिक टूल है, जिसे हैदराबाद की स्टार्टअप कंपनी क्विक विटल्स ने डिवेलप किया है. यह तकनीक ट्रांसडर्मल ऑप्टिकल इमेजिंग (टीओआई) और मशीन लर्निंग के मैथड पर काम करती है.
4/7

इस टूल में एक हाई-रिज़ॉल्यूशन कैमरा और सेंसर लगे होते हैं, जो चेहरे की स्किन के ब्लड फ्लो में होने वाले छोटे-छोटे बदलावों को कैप्चर करते हैं.
5/7

इन बदलावों का परखने के बाद यह टूल कई हेल्थ मानकों जैसे ब्लड प्रेशर, हार्ट रेट, हीमोग्लोबिन लेवल, ऑक्सीजन सैचुरेशन और टेंशन के लेवल की जानकारी देता है.
6/7

इस तकनीक का पहला सफल ट्रायल नीलोफर अस्पताल में किया गया, जहां बच्चों और गर्भवती महिलाओं पर इसका परीक्षण किया गया.
7/7
अस्पताल के सीएमओ डॉ. प्रभाकर रेड्डी ने बताया कि इस तकनीक ने 95% से अधिक सटीक नतीजे दिए हैं, जो पारंपरिक ब्लड टेस्ट के बराबर हैं. उन्होंने कहा, 'यह तकनीक उन मरीजों के लिए वरदान साबित होगी, जो सुई से डरते हैं या जिन्हें बार-बार ब्लड टेस्ट करवाने पड़ते हैं.'
Published at : 29 May 2025 05:08 PM (IST)
और देखें
टॉप हेडलाइंस
इंडिया
दिल्ली NCR
बॉलीवुड
क्रिकेट
























